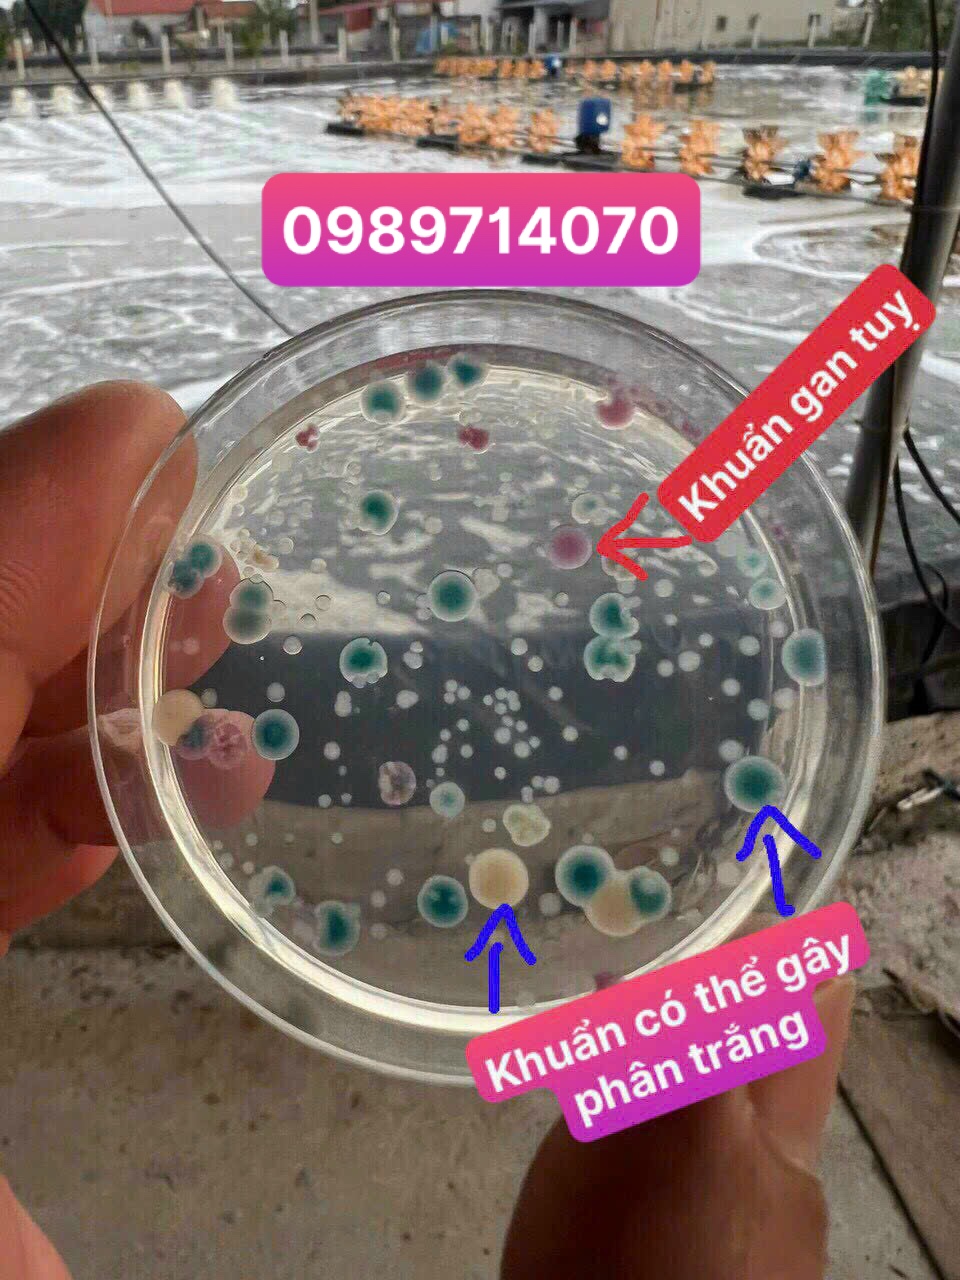

MẬT SỐ VI KHUẨN TRONG AO CAO SẼ ẢNH HƯỞNG ĐẾN TÔM NHƯ THẾ NÀO
Đối với vi khuẩn có lợi, việc chúng phát triển nhanh chóng, thuận lợi ở môi trường nước ao nuôi đem lại rất nhiều lợi ích cho người nuôi tôm. Ở một số ao, nếu mật độ vi khuẩn có lợi ít hoặc làm việc kém hiệu quả, người nuôi nên bổ sung thêm để giúp hỗ trợ ao nuôi ổn định, tôm phát triển khỏe mạnh hơn.
Ngược lại, nếu vi khuẩn gây hại phát triển với mật độ dày đặc, đây là tình trạng đáng báo động cho ao nuôi cũng như sức khỏe tôm đang sinh trưởng tại ao.
Một số dấu hiệu cơ bản để nhận thấy tôm bị nhiễm khuẩn Vibrio như:
- Lờ đờ
- Bỏ ăn
- Gan tụy bị mất màu dần và hoại tử
- Cơ thể tôm hơi đỏ,
- Vàng mô mang,
- Xuất hiện các mảng trắng ở cơ bụng,
- Gây hiện tượng Melanin hóa (xuất hiện đốm đen)
- Khối u có vỏ bọc dạng hạt trên cơ thịt tôm
- Các cơ quan khác nhau bị hoại tử và tổn thương, chẳng hạn như cơ quan sản xuất lympho, mang, tim,...
- Gây ra hiện tượng phát sáng
Đĩa chromagar giúp kiểm tra khuẩn gây hại trong ao
Trong nuôi tôm thẻ chân trắng, vi khuẩn Vibrio có liên quan đến một số bệnh nguy hiểm nhất như:
- Vibrio harveyi có liên quan đến bệnh phát sáng là mầm bệnh chính tấn công ấu trùng tôm và gây chết hàng loạt.
- V. vulnificus, V. fluvialis, V. parahaemolyticus, V. alginolyticus, V. damselae (Photobacterium damselae), V. mimicus và V. cholera có liên quan đến bệnh phân trắng (WFD) – bệnh ảnh hưởng nặng nề đến nhiều nước sản xuất tôm.
- V. parahaemolyticus cũng là nguyên nhân hàng đầu gây ra EMS / AHPND
- Bệnh TPD do V. parahaemolyticus có gen độc lực cao gấp 1000 lần chủng gây bệnh EMS
Chúng tăng sinh nhanh trong môi trường ao nuôi, trung bình cứ 20 phút số lượng Vibrio lại được nhân lên gấp đôi. Thậm chí khi dùng kháng sinh hay diệt khuẩn tiêu diệt 99,99% Vibrio đã bị tiêu diệt thì 0,01% còn lại trong vòng 5 – 6 giờ với điều kiện thuận lợi chúng vẫn tiếp tục phát triển, sinh sôi và khôi phục số lượng như ban đầu, rất nguy hiểm nếu trong ao vẫn còn tồn tại vi khuẩn vibrio.
Để ức chế khuẩn gây hại hiệu quả bà con nên dùng men vi sinh viên Pro4000X Plus 6 viên/1.000m3 xen kẻ với men Pond Clear 1 gói/2.000m3 vào lúc 8h sáng để khống chế mật số vibrio trong ngưỡng cho phép.
Trong trường hợp khuẩn cao bà con nên sử dụng hóa chất diệt khuẩn an toàn và hiệu quả cho tôm như Vikon Gold 1kg/1.000m3, Brocid 1L/1.000m3, Super Clear 1L/1.000m3, sau 24h kiểm tra bằng kiểm kiểm khuẩn, nếu khuẩn còn cao lặp lại liều 2.
Vì vậy, định kỳ bà con nên kiểm tra mật số khuẩn vibrio trong nước bằng đĩa kiểm khuẩn TCBS hoặc Chromagar từ đó có biện pháp xử lý kịp thời.
Bà con cần tư vấn hoặc hỗ trợ kỹ thuật vui lòng liên hệ 0989714070 hoặc 0983 69 15 15 để được kỹ thuật viên hỗ trợ!
Chúc Quý bà con mùa vụ bội thu!